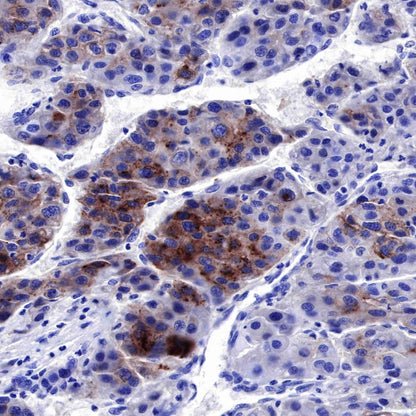

Product Specification
| Host |
Rabbit |
| Antigen |
AFP |
| Synonyms |
Alpha-fetoprotein |
| Immunogen |
N/A |
| Location |
Secreted |
| Accession |
P02771 |
| Clone Number |
SDT-R077 |
| Antibody Type |
Rabbit mAb |
| Application |
WB, IHC-P, ICC, IP |
| Reactivity |
Hu |
| Purification |
Protein A |
| Concentration |
0.25 mg/ml |
| Physical Appearance |
Liquid |
| Storage Buffer |
PBS, 40% Glycerol, 0.05%BSA, 0.03% Proclin 300 |
| Stability & Storage |
12 months from date of receipt / reconstitution, -20 °C as supplied |
Dilution
| application |
dilution |
species |
| WB |
1:500-1:1000 |
|
| IHC-P |
1:1000 |
|
| IP |
1:25 |
|
| ICC |
1:250 |
|
Background
Hepatocarcinoma is one of the most prevalent gastroenterological cancers in the world with less effective therapy. As an oncofetal antigen and diagnostic marker for liver cancer, alpha-fetoprotein (AFP) possesses a variety of biological functions. Except for its diagnosis in liver cancer, AFP has become a target for liver cancer immunotherapy. Although the immunogenicity of AFP is weak and it could induce the immune escapes through inhibiting the function of dendritic cells, natural killer cells, and T lymphocytes, AFP has attracted more attention in liver cancer immunotherapy.